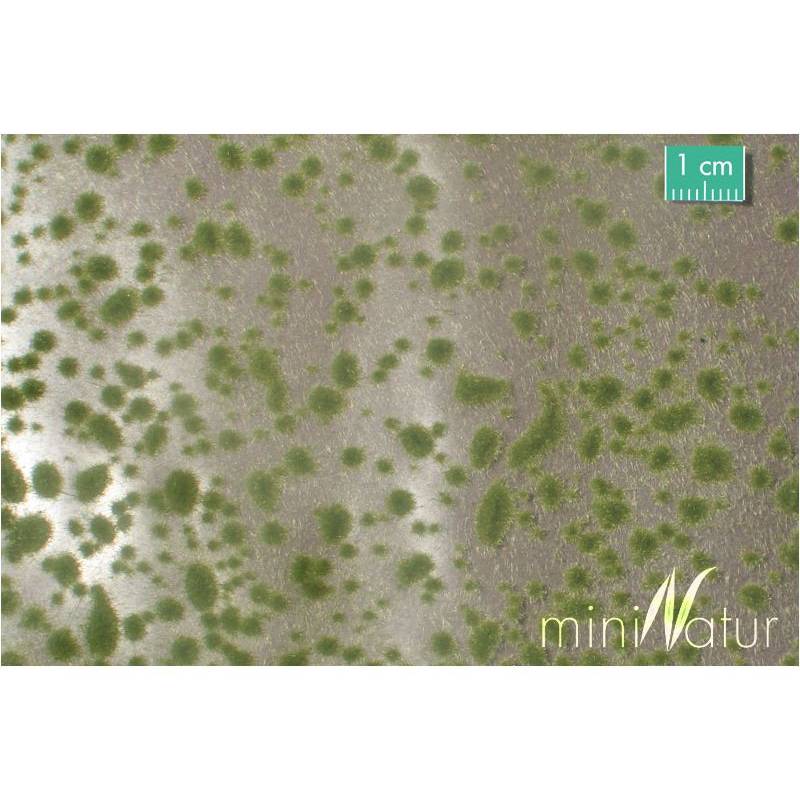
MiniNatur 747-23 S - Moospolster - Frühherbst

Karussellbehälter
Anmelden & Kostenlos anmelden
Alle Kategorie
- All manufacturers
- A.C.M.E
- AMF 87
- Architecture & Passion
- Arnold
- Artitec
- AZAR MODELS
- Bachmann
- Boutique Train
- Busch
- Castorland Puzzle
- CHREZO
- Colle 21
- Creatifwood
- DAMOFER
- Digikeijs
- Doehler & Haass
- Electrotren
- EPM Productions
- ESU
- Evergreen
- Exact-train
- FALLER
- Fleischmann
- Haxo Modèle
- Heki
- HELJAN
- heller
- HERPA
- HOBBYTRAIN
- Hornby
- Humbrol
- Jouef
- Kato
- Kolibri
- L.S.Models
- Lenz
- LGB
- Lima
- LR PRESSE
- LUX-Modellbau
- Maquette Création
- Märklin
- Märklin My World
- Metcalfe
- MF Train
- Microrama
- MiniNatur
- Minitrains
- MINITRIX
- Modelbex
- Models World
- Mozabrick
- MTB
- MTH
- NOCH
- Novateur Modèles
- Os.kar international
- Peco
- Piko
- Preiser
- Prince August
- R37
- REE
- Rivarossi
- Rocky-Rail
- Roco
- Sprog DCC
- Tamiya
- TILLIG
- Toma Model Works
- Train-O-Matic
- Trains 160
- Trix
- Vallejo
- ViTrains
- woodlandscenics
- OCCASION
- Sur commande et paiement d'avance
- Promotions du moment
- Nouveautés 2023
- Züge
- Schienen
- Coffrets
- Peintures
- Kolibri
- Ruban de masquage
- Diluant et nettoyant
- Peinture ferroviaires
- Humbrol
- Peinture Vallejo
- Paysage et décors
- Prince August Classique
- Prince August Air
- Prince August Games
- Prince August-Polyuréthane
- Prince August Base
- Prince August - Métal Color
- Prince August Patine
- Prince August Pinceaux
- Prince August Coffrets
- Prince August Aéro
- Prince August Moulage
- Éclairage
- Pièces détachées
- Outillage
- Le Digital
- Fil - Câble - Gaines thermorétractables
Karussellbehälter
-
Home
- Züge
- Promotions du moment
- Nouveautés 2023
-
Le Digital
-
Schienen
-
Maquettes
- Architecture & Passion
- Artitec
- BUSCH
- Chargement : cadres, conteneurs, Etc.
- Colle 21
- Evergreen
- Faller
- Games-Workshop
- Maquettes
- Maquette Création
- Martin Welberg
- Metcalfe
- Microrama
- Model Scene
- NOCH
- Peco
- Preiser
- PUZZLES
- Kato - décor
- RATIO
- REE-ASPHALTE87
- Tamiya
- WILLS-KITS
- Woodlandscenics
- Heller
- MiniNatur
- SAI
- HERPA
- Huisseries
- OCCASION
-
Peintures
- Kolibri
- Ruban de masquage
- Diluant et nettoyant
- Peinture ferroviaires
- Humbrol
- Peinture Vallejo
- Paysage et décors
- Prince August Classique
- Prince August Air
- Prince August Games
- Prince August-Polyuréthane
- Prince August Base
- Prince August - Métal Color
- Prince August Patine
- Prince August Pinceaux
- Prince August Coffrets
- Prince August Aéro
- Prince August Moulage
- Coffrets
- Réservations
- Kato
- Fil - Câble - Gaines thermorétractables
- Éclairage
- Accessories
- Brand
- Pièces détachées
- Univers
- Outillage
- Sur commande et paiement d'avance
- Coffrets trains
-
Schienen
- Züge
-
Maquettes
- Architecture & Passion
- Artitec
- BUSCH
- Chargement : cadres, conteneurs, Etc.
- Colle 21
- Evergreen
- Faller
- Games-Workshop
- Maquettes
- Maquette Création
- Martin Welberg
- Metcalfe
- Microrama
- Model Scene
- NOCH
- Peco
- Preiser
- PUZZLES
- Kato - décor
- RATIO
- REE-ASPHALTE87
- Tamiya
- WILLS-KITS
- Woodlandscenics
- Heller
- MiniNatur
- SAI
- HERPA
-
Peintures
- Kolibri
- Ruban de masquage
- Diluant et nettoyant
- Peinture ferroviaires
- Humbrol
- Peinture Vallejo
- Paysage et décors
- Prince August Classique
- Prince August Air
- Prince August Games
- Prince August-Polyuréthane
- Prince August Base
- Prince August - Métal Color
- Prince August Patine
- Prince August Pinceaux
- Prince August Coffrets
- Prince August Aéro
- Prince August Moulage
Contact : (+33) 2 97 51 39 51
MiniNatur 747-23 S - Moospolster - Frühherbst
4 x 30 cm
 Garanties sécurité
Garanties sécurité
(à modifier dans le module "Réassurance")
 Politique de livraison
Politique de livraison
(à modifier dans le module "Réassurance")
 Politique retours
Politique retours
(à modifier dans le module "Réassurance")
Kommentare (0)
Aktuell keine Kunden-Kommentare
Ihre Bewertung der Rezension kann nicht gesendet werden
Kommentar melden
Möchten Sie diesen Kommentar wirklich melden?
Meldung gesendet
Ihre Meldung wurde übermittelt und wird durch einen Moderator geprüft.
Ihre Meldung kann nicht gesendet werden
Eigenen Kommentar verfassen
Bewertung gesendet
Ihr Kommentar wurde gespeichert und wird sofort nach Freigabe durch einen Moderator angezeigt.
Ihre Bewertung kann nicht gesendet werden
4 x 30 cm


